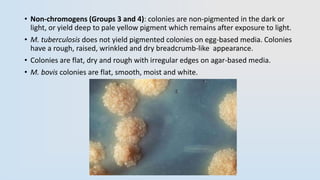
• Non-chromogens (Groups 3 and 4): colonies are non-pigmented in the dark or
light, or yield deep to pale yellow pigment which remains after exposure to light.
• M. tuberculosis does not yield pigmented colonies on egg-based media. Colonies
have a rough, raised, wrinkled and dry breadcrumb-like appearance.
• Colonies are flat, dry and rough with irregular edges on agar-based media.
• M. bovis colonies are flat, smooth, moist and white.

This document provides information about Mycobacteria, including:
- They are acid-fast bacteria that cause diseases like tuberculosis and leprosy.
- Mycobacteria have a thick, waxy cell wall that makes them resistant to antibiotics and able to survive inside host cells.
- Diseases are diagnosed through microscopy, culture, mantoux tests, and chest x-rays. High rates of tuberculosis infection occur in developing regions of Africa, Asia, and the Pacific.